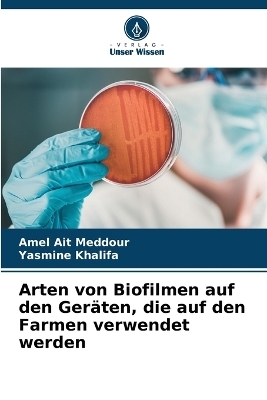
Arten von Biofilmen auf den Ger&auml;ten, die auf den Farmen verwendet werden - Amel Ait Meddour, Yasmine Khalifa

Arten von Biofilmen auf den Geräten, die auf den Farmen verwendet werden
Seiten
2023
Verlag Unser Wissen
978-620-6-02557-3 (ISBN)
Verlag Unser Wissen
978-620-6-02557-3 (ISBN)
- Keine Verlagsinformationen verfügbar
- Artikel merken
Ein Biofilm ist eine sessile mikrobielle Gemeinschaft auf einer lebenden oder inerten Oberfläche. In Milchviehbetrieben bilden sich Biofilme unweigerlich auf feuchten Materialoberflächen. Es gibt zwei Arten, den positiven Biofilm, der aus technologisch interessanten Floren wie Milchsäurebakterien besteht, die eine wichtige Rolle bei der Verhinderung der Anhaftung von pathogenen Mikroorganismen spielen, und den negativen Biofilm, der ausVerderbnis- und pathogenen Floren besteht. Der negative Biofilm kann sich von der Ausrüstung ablösen und die Rohmilch kontaminieren, was zu einer Beeinträchtigung der organoleptischen Qualität führt und schwere Krankheiten verursachen kann.
Name-Vorname: AIT MEDDOUR AmelDienstgrad: Maitre de Conférences-Klasse A
| Erscheinungsdatum | 22.06.2023 |
|---|---|
| Sprache | deutsch |
| Maße | 152 x 229 mm |
| Gewicht | 103 g |
| Themenwelt | Naturwissenschaften ► Biologie ► Allgemeines / Lexika |
| Naturwissenschaften ► Biologie ► Mikrobiologie / Immunologie | |
| Schlagworte | bäuerliche Werkstätten. • Milchsäurebakterien • negativer Biofilm • positiver Biofilm |
| ISBN-10 | 620-6-02557-8 / 6206025578 |
| ISBN-13 | 978-620-6-02557-3 / 9786206025573 |
| Zustand | Neuware |
| Informationen gemäß Produktsicherheitsverordnung (GPSR) | |
| Haben Sie eine Frage zum Produkt? |
Mehr entdecken
aus dem Bereich
aus dem Bereich
Buch | Softcover (2024)
Wiley-VCH (Verlag)
CHF 55,85
Vom Ursprung der Sexualitat zum modernen Menschen
Buch | Softcover (2025)
UTB (Verlag)
CHF 54,60


